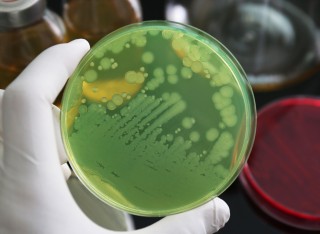

Dr Jorge Gutierrez-Merino
Academic and research departments
School of Veterinary Medicine, Faculty of Health and Medical Sciences.About
Biography
1994-2000: Doctor of Veterinary Medicine, School of Veterinary Medicine, Universidad Complutense de Madrid, Spain. Final year practicals at the Zoological Park of Madrid and abattoirs.
2000-2005: Master/PhD student at the School of Veterinary Medicine, Universidad Complutense de Madrid, Spain, where I managed to overproduce bacteriocins from lactic acid bacteria in heterologous hosts of interest in the food industry. In collaboration with the Biotechnology Research Institute, National Research Council of Canada, Montreal, Canada; and the Biomolecular Sciences and Biotechnology Institute, University of Groningen, the Netherlands.
2006-2010: Postdoctoral Researcher in Ireland; first placement at the School of Food Science and Environmental Health, Dublin Institute of Technology, where I investigated the potential of essential oils as natural preservatives against food-borne pathogens and spoilage bacteria associated with minimally processed food; second placement at the School of Veterinary Medicine, University College Dublin, where I developed and validated a real time PCR test as a diagnostic tool for the detection of Chlamydophila abortus and Toxoplasma gondii, the two leading infectious causes of ovine abortion in Ireland and UK.
2010-2013: Researcher in Spain; first placement at the Salamanca Institute of Natural Resources and Agrobiology, Spanish Research Council, where I worked on transcriptional responses of plant cells under photo-oxidative stress; second placement at the Cantabria Institute of Biomedicine and Biotechnology, Santander, where I was involved in a project focused on drug discovery by using biosynthetic engineering in Streptomyces.
Areas of specialism
University roles and responsibilities
- Programme Leader for BSc (Hons) Veterinary Biosciences
Affiliations and memberships
Business, industry and community links
News
ResearchResearch interests
My main research interest is focused on optimising the use of lactic acid bacteria (LAB) as beneficial commensal bacteria to mitigate the negative impact of gut infectious diseases and other inflammatory disorders. LAB provide a beneficial effect on mammalian gut cells in numerous ways as they defend against colonization of opportunistic bacterial pathogens and maintain a favourable intestinal microbial balance. One of my objectives is to exploit competitive microbial environments for the isolation of LAB with relevant antimicrobial activity against bacterial pathogens, and understand the mechanisms that these commensal bacteria use to modulate the host innate immune response in order to enhance vaccination and/or reduce gut inflammatory processes.
Research collaborations
Animal Health Veterinary Laboratories (AHVL) Agency
Research interests
My main research interest is focused on optimising the use of lactic acid bacteria (LAB) as beneficial commensal bacteria to mitigate the negative impact of gut infectious diseases and other inflammatory disorders. LAB provide a beneficial effect on mammalian gut cells in numerous ways as they defend against colonization of opportunistic bacterial pathogens and maintain a favourable intestinal microbial balance. One of my objectives is to exploit competitive microbial environments for the isolation of LAB with relevant antimicrobial activity against bacterial pathogens, and understand the mechanisms that these commensal bacteria use to modulate the host innate immune response in order to enhance vaccination and/or reduce gut inflammatory processes.
Research collaborations
Animal Health Veterinary Laboratories (AHVL) Agency
Teaching
Undergraduate
I teach on the following courses:
I teach on the following modules:
- Food Science and Nutrition (BMS1027)
- Food Chemistry (BMS3059)
- Food Technology and Safety (BMS3070)
- Food Quality Assurance and Food Security (BMS3071)
- Food Microbiology (BMS2041)
- International and Public Health Nutrition (BMS3058)
- Animal Infectious Diseases and Veterinary Public Health (BMS3074).
Postgraduate
I teach on the following courses:
- Human Nutrition MSc
- Veterinary Microbiology MSc.
I teach on the following modules:
- MHUM004: International and Public Health Nutrition
- MMVM007: Diseases of Animal Systems: Gastrointestinal Diseases of Animals.
Sustainable development goals
My research interests are related to the following:



Publications
The gut microbiome plays a critical role in health, disease and immunity. To date, we have access to large datasets describing how the microbial diversity present in the gut correlates with many clinical conditions. However, the microbiome composition is taxonomically complex; influenced by many environmental factors; and variable between individuals and communities, thereby limiting functional and mechanistic insights into the microbiota‒host interactions. We are still unsure of the molecular mechanisms by which gut commensal microbes intrinsically possess to interact with the immune system and induce beneficial responses. This study has addressed this important question by revealing that only certain members of , a bacterial family very well known for its probiotic properties, interact very intimately with macrophages because of their ability to simultaneously overexpress adhesive cell wall proteins and to self-aggregate, leading to significant production of type I interferon (IFN-I) cytokines. IFN-I cytokines are essential to confer protection against viral infections and auto-immune disorders. Specifically, we have proved that this enhanced IFN-I feature is strain-dependent and predominantly driven by cGAS, a molecule that activates the cytosolic sensor STING upon the recognition of bacterial DNA. Furthermore, another cytosolic sensor, NOD2, seems to be an additional stimulus to amplify IFN-I production, suggesting the involvement of successive molecular events for a prominent probiotic response. Our findings provide insight into how specific molecules of probiotic bacteria modulate or stimulate host responses, providing a better understanding of the molecular crosstalk between the microbiome and immune cells.
In this work we have developed hierarchically porous phosphate-based glasses (PPGs), as novel materials capable of promoting wound closure and simultaneously deliver antibacterial effects at the interface glass-biological tissue. PPGs are characterised by extended porosity which enhances the release of therapeutic ions in a controlled way, whilst facilitating cell infiltration and growth of tissues. Two series of PPGs in the systems P2O5-CaO-Na2O-CuO and P2O5-CaO-Na2O-Ga2O3 with (CuO and Ga2O3 0, 1, 5 and 10 mol %) were manufactured using a supramolecular sol-gel synthesis strategy. Significant wound healing promotion (up to 97 %) was demonstrated using a human ex vivo wound model. A significant statistical reduction of the bacterial strains Staphylococcus aureus and Escherichia coli was observed in both series of PPGs, particularly those containing copper. All PPGs present good cytocompatibility on keratinocytes (HaCaTs) and analysis of dissolution products of PPGs over a 7-day period demonstrates controlled release of phosphate anions and Ca, Na, Cu, and Ga cations. These findings indicate that Cu- and Ga-loaded PPGs are promising materials for applications in soft tissue regeneration given their antibacterial capabilities, in vitro biocompatibility on keratinocytes and ex vivo wound healing properties at the interface biomaterial-human tissue. Keywords: phosphate-based glasses, gallium, copper, tissue engineering, sol-gel, bioresorbable glasses, antibacterial, in vitro, ex vivo, hierarchically porous.
•A multi-frequency study of ultrasound (US) and nisin for microbial inactivation.•US impacts E. coli at 500 kHz only; L. innocua resists all frequencies studied.•Nisin applied before US enhances inactivation of E. coli but not when applied after.•Attributed to outer membrane destabilisation by US allowing nisin penetration.•System structure (viscosity) reduces US inactivation efficacy. Ultrasound, alone or in combination with natural antimicrobials, is a novel food processing technology of interest to replace traditional food decontamination methods, as it is milder than classical sterilisation (heat treatment) and maintains desirable sensory characteristics. However, ultrasound efficacy can be affected by food structure/composition, as well as the order in which combined treatments are applied. More specifically, treatments which target different cell components could result in enhanced inactivation if applied in the appropriate order. The microbial properties i.e. Gram positive/Gram negative can also impact the treatment efficacy. This work presents a systematic study of the combined effect of ultrasound and nisin on the inactivation of the bacteria Listeria innocua (Gram positive) and Escherichia coli (Gram negative), at a range of cavitation conditions (44, 500, 1000 kHz). The order of treatment application was varied, and the impact of system structure was also investigated by varying the concentration of Xanthan gum used to create the food model systems (0 – 0.5% w/v). Microbial inactivation kinetics were monitored, and advanced microscopy and flow cytometry techniques were utilised to quantify the impact of treatment on a cellular level. Ultrasound was shown to be effective against E. coli at 500 kHz only, with L. innocua demonstrating resistance to all frequencies studied. Enhanced inactivation of E. coli was observed for the combination of nisin and ultrasound at 500 kHz, but only when nisin was applied before ultrasound treatment. The system structure negatively impacted the inactivation efficacy. The combined effect of ultrasound and nisin on E. coli was attributed to short-lived destabilisation of the outer membrane as a result of sonication, allowing nisin to penetrate the cytoplasmic membrane and facilitate cell inactivation.
The substitution of chemical preservatives with natural antimicrobials has emerged as an important topic of interest for both researchers and the food industry. The utilisation of grape seed extract (GSE) has the potential to serve as an effective natural antimicrobial agent, while also offering the advantage of being a sustainable antimicrobial strategy, since GSE is a by-product of the fruit industry. The aim of this study was to quantitatively investigate the antimicrobial efficacy of GSE (1 % w/v) that was added in xanthan gum (XG)-based viscoelastic models of various XG concentrations (3, 5, 7% w/v XG) against the wild-type (WT) strain and isogenic ΔsigB mutant of the foodborne pathogen L. monocytogenes. The gene regulator SigB is responsible for the general stress response of L. monocytogenes and its adaptation to environmental stresses. The GSE treatment effectively inactivated both strains (microbial inactivation ≥ 3 log CFU/ml) in all viscoelastic models regardless of the model firmness. However, the mutant strain ΔsigB was more sensitive to GSE treatment evidenced by the reduced viable population count and the increased percentage of sublethal injury in comparison to the WT. Lastly, at 7 % w/v XG (GSE-free) concentration, which was the highest gelling agent concentration used in this study, the mutant formed smaller colonies on the model surface as compared to the WT, suggesting the impact of SigB on the microbial growth/colony formation, especially on stiffer surfaces. The results of our study shed light on the impact of matrix surface structure on the response of L. monocytogenes and its ΔsigB mutant to the waste product GSE. Therefore, this study contributes to the development of enhanced and sustainable antimicrobial control strategies.
This study investigates a series of phosphate-glass fibres (PGF) in the system P2O5-CaO-MgONa2O-Fe2O3 with various Fe content (0, 0.1, 0.5, 1 and 2 weight %) prepared via electrospinning (ES) of polyphosphate coacervate gels. This method is preferable over the traditional high temperature melt-spinning technique (MS) used for PGF production as it represents a more cost-effective and sustainable route. Structural analysis performed via Fourier Transform Infrared spectroscopy (FT-IR) shows that PGF are mainly formed by polyphosphate chains containing Q1 and Q2 units. Thermal analysis demonstrates that the amorphous nature of PGF can be preserved up to calcination temperatures in the range 450-520 °C, with crystallisation temperatures increasing with the iron content. Dissolution studies were performed by immersing the PGF in deionised (DI) water and analysing the species released (P, Ca, Mg, Fe and Na) via Microwave Plasma Atomic Emission Spectroscopy (MP-AES) at regular intervals up to 72 hours (h). Results show that both iron and phosphate anions release increases with iron loading, suggesting that the phosphate network is weakened by an increasing amount of iron. Given that PGF are particularly advantageous in wound healing due to their fibrous morphology, their cytocompatibility was assessed by seeding human keratinocytes (HaCaTs) in contact with the dissolution products of PGF after 24 h of immersion at three different ratios of dissolution products to cell medium (1:100, 3:100 and 5:100). No cytotoxicity was observed for any of the ratios studied. Moreover, the dissolution products of some PGF resulted in an enhanced growth of HaCaT cells, with the best result being observed when using dissolution products from PGF containing 0.1 weight % of Fe and a dissolution product - cell medium ratio of 5:100. Dissolution products from PGF with an Fe content up to 0.5 weight % have also demonstrated antibacterial activity against the bacterium Escherichia coli (E. coli). A preliminary test on the efficacy of PGF in wound healing via ex vivo studies on human skin has demonstrated that PGF in direct contact with the wound promotes 84 % wound closure.
The aim of the current study is to develop and characterise novel complex multi-phase in vitro 3D models, for advanced microbiological studies. More specifically, we enriched our previously developed bi-phasic polysaccharide (Xanthan Gum)/protein (Whey Protein) 3D model with a fat phase (Sunflower Oil) at various concentrations, i.e., 10%, 20%, 40% and 60% (v/v), for better mimicry of the structural and biochemical composition of real food products. Rheological, textural, and physicochemical analysis as well as advanced microscopy imaging (including spatial mapping of the fat droplet distribution) of the new tri-phasic 3D models revealed their similarity to industrial food products (especially cheese products). Furthermore, microbial growth experiments of foodborne bacteria, i.e., Listeria monocytogenes, Escherichia coli, Pseudomonas aeruginosa and Lactococcus lactis on the surface of the 3D models revealed very interesting results, regarding the growth dynamics and distribution of cells at colony level. More specifically, the size of the colonies formed on the surface of the 3D models, increased substantially for increasing fat concentrations, especially in mid- and late-exponential growth phases. Furthermore, colonies formed in proximity to fat were substantially larger as compared to the ones that were located far from the fat phase of the models. In terms of growth location, the majority of colonies were located on the protein/polysaccharide phase of the 3D models. All those differences at microscopic level, that can directly affect the bacterial response to decontamination treatments, were not captured by the macroscopic kinetics (growth dynamics), which were unaffected from changes in fat concentration. Our findings demonstrate the importance of developing structurally and biochemically complex 3D in vitro models (for closer proximity to industrial products), as well as the necessity of conducting multi-level microbial analyses, to better understand and predict the bacterial behaviour in relation to their biochemical and structural environment. Such studies in advanced 3D environments can assist a better/more accurate design of industrial antimicrobial processes, ultimately, improving food safety.
Reactive oxygen and nitrogen species (RONS) are emerging as a novel antibacterial strategy to combat the alarming increase in antimicrobial resistance (AMR). RONS can inhibit bacterial growth through reactions with cellular molecules, compromising vital biological functions and leading to cell death. While their mechanisms of action have been studied, many remain unclear, especially in biologically relevant environments. In this study, we exposed Gram-positive and Gram-negative bacteria to varying RONS ratios, mimicking what microbes may naturally encounter. A ratio in favour of RNS induced membrane depolarization and pore formation, resulting in an irreversible bactericidal effect. By contrast, ROS predominance caused membrane permeabilization and necrotic-like responses, leading to biofilm formation. Furthermore, bacterial cells exposed to more RNS than ROS activated metabolic processes associated with anaerobic respiration, DNA & cell wall/membrane repair, and cell signalling. Our findings suggest that the combination of ROS and RNS can be an effective alternative to inhibit bacteria, but only under higher RNS levels, as ROS dominance might foster bacterial tolerance, which in the context of AMR could have devastating consequences.
Understanding and predicting bacterial behaviour in foods is vital for food safety. Although in the past most food microbiological research was conducted in liquids, it is now known that bacterial behaviour changes fundamentally when grown in structured environments. Furthermore, the bacterial behaviour is also affected by the natural microflora of foods and possible cross-contaminants. These can interact synergistically but can also be used as an antagonistic tool for food safety. The aim of this work is to perform a systematic study on the impact of fat concentrations (FC) on bacterial kinetics, their inter-species interactions, and their sensitivity towards the mild preservation technology of cold atmospheric plasma (CAP) in complex triphasic 3D systems. Building on our biphasic protein/polysaccharide food model (FM), a third fat phase was incorporated into the system (10-60%). Single-cultures of Listeria monocytogenes, Escherichia coli, Pseudomonas aeruginosa and Lactococcus lactis were grown on the surface of the FMs, as well as listerial co-cultures with each of the listed bacterium. A multiscale analysis took place macroscopically (plate count) and microscopically (confocal-laser-scanning-microscopy). Subsequently, the single- and co-cultures grown on the FMs surfaces were treated with CAP. Overall, the macroscopic analysis revealed increased growth of single cultures in comparison to co-cultures, but no significant impact in respect to the tested FCs. However, on the microscopic scale, generally, differences between the FCs were observed. More specifically, the bacterial colony sizes and biofilm formation were increased with increasing FC, more significant in co-cultures than in single-cultures. Due to these microscopic differences, a different level of cell-to-cell and colony-to-colony interaction takes place. This was further demonstrated by the susceptibility and resistance of the single- and co-cultures to the CAP treatment. In conclusion, our results indicate the importance of accounting for the microflora complexity and their interactions in food systems when predicting microbial behaviour and designing food decontamination treatments to ensure food safety.
There is an increasing demand for new biomaterials that both rapidly stimulate healing and prevent infections. Being bioresorbable, phosphate-glass fibres can simultaneously induce tissue regeneration and deliver therapeutic agents (e.g. antibacterial ions) in a controlled way. Here we present a series of copper-doped phosphate-based glass fibres in the P2O5-CaO-Na2O-(CuO)x system (x = 0, 1, 3, and 5 mol%) prepared for the first time via electrospinning of coacervate precursors. This method presents several advantages over the conventional high temperature melt spinning; the synthesis of the coacervate occurs at room temperature and in aqueous solution allowing the incorporation of temperature sensitive molecules. Moreover, electrospinning is an inexpensive, sustainable, easily scalable manufacturing process. The fibres produced are cotton-like, fully amorphous with an average diameter in the range 1–3 µm. Dissolution studies on cations (Ca2+, Na+ and Cu2+) and phosphate anions (PO43−, P2O74−, and P3O105−) show a gradual release of all species in solution over time, ideal for controlled drug delivery applications. The antibacterial activity against both Gram-positive (Staphylococcus aureus) and Gram-negative (Escherichia coli) bacteria was found to increase with increasing Cu2+ content and was found to be more effective against E. coli than against S. aureus. Interestingly, Cu2+ content seem to have a positive effect on cytocompatibility. Tests performed on osteoblast-like MG63 osteosarcoma cells have shown that the copper doped phosphate-glass fibres have a significantly better capacity to regenerate bone tissue than the undoped glass fibres. These findings suggest that phosphate-based glass fibres are promising multifunctional biomaterials for both antibacterial activity and tissue regeneration. [Display omitted]
There is a great demand from patients requiring skin repair, as a result of poorly healed acute wounds or chronic wounds. These patients are at high risk of constant inflammation that often leads to life-threatening infections. Therefore, there is an urgent need for new materials that could rapidly stimulate the healing process and simultaneously prevent infections. Phosphate-based coacervates (PC) have been the subject of increased interest due to their great potential in tissue regeneration and as controlled delivery systems. Being bioresorbable, they dissolve over time and simultaneously release therapeutic species in a continuous manner. Of particular interest is the controlled release of metallic antibacterial ions (e.g. Ag+), a promising alternative to conventional treatments based on antibiotics, often associated with antibacterial resistance (AMR). This study investigates a series of PC gels containing a range of concentrations of the antibacterial ion Ag+ (0.1, 0.3 and 0.75 mol%). Dissolution tests have demonstrated controlled release of Ag+ over time, resulting in a significant bacterial reduction (up to 7 log), against both non-AMR and AMR strains of both Gram-positive and Gram-negative bacteria (Staphylococcus aureus, Enterococcus faecalis, Escherichia coli and Pseudomonas aeruginosa). Dissolution tests have also shown controlled release of phosphates, Ca2+, Na+ and Ag+ with most of the release occurring in the first 24 h. Biocompatibility studies, assessed using dissolution products in contact with human keratinocyte cells (HaCaT) and bacterial strains, have shown a significant increase in cell viability (p ≤ 0.001) when gels are dissolved in cell medium compared to the control. These results suggest that gel-like silver doped PCs are promising multifunctional materials for smart wound dressings, being capable of simultaneously inhibit pathogenic bacteria and maintain good cell viability.
Epidemiological studies show that higher circulating levels of odd chain saturated fatty acids (FA: C15:0 and C17:0) are associated with lower risk of metabolic disease. These odd chain saturated fatty acids (OCSFA) are produced by α-oxidation in peroxisomes, de novo lipogenesis, from the diet and by gut microbiota. Although present at low concentrations, they are of interest as potential targets to reduce metabolic disease risk. To determine whether OCSFA are affected by obesogenic diets, we have investigated whether high dietary fat intake affects the frequency of OCSFA-producing gut microbiota, liver lipid metabolism genes and circulating OCSFA. FA concentrations were determined in liver and serum from pathogen-free SPF C57BL/6 J mice fed either standard chow or a high fat diet (HFD; 60% calories as fat) for four and twelve weeks. Post-mortem mouse livers were analysed histologically for fat deposition by gas chromatography–mass spectrometry for FA composition and by qPCR for the lipid metabolic genes fatty acid desaturase 2 (FADS2), stearoyl CoA desaturase 1 (SCD1), elongation of long-chain fatty acids family member 6 (ELOVL6) and 2-hydroxyacyl-CoA lyase 1 (HACL). Gut microbiota in faecal pellets from the ileum were analysed by 16S RNA sequencing. A significant depletion of serum and liver C15:0 (>50%; P 35%; P 50%; P
Biomaterials capable of promoting wound healing and preventing infections remain in great demand to address the global unmet need for the treatment of chronic wounds. Phosphate-based glasses (PG) have shown potential as bioresorbable materials capable of inducing tissue regeneration, while being replaced by regenerated tissue and releasing therapeutic species. In this work, phosphate-glass-based fibers (PGF) in the system P2O5–CaO–Na2O added with 1, 2, 4, 6, and 10 mol % of the therapeutic metallic ions (TMI) Ag+, Zn2+, and Fe3+ were manufactured via electrospinning of coacervate gels. Coacervation is a sustainable, cost-effective, water-based method to produce PG. All TMI are effective in promoting wound closure (re-epithelialization) in living human skin ex vivo, where the best-performing system is PGF containing Ag+. In particular, PGF with ≥4 mol % of Ag+ is capable of promoting 84% wound closure over 48 h. These results are confirmed by scratch test migration assays, with the PGF-Ag systems containing ≥6 mol % of Ag+, demonstrating significant wound closure enhancement (up to 72%) after 24 h. The PGF-Ag systems are also the most effective in terms of antibacterial activity against both the Gram-positive Staphylococcus aureus and the Gram-negative Escherichia coli. PGF doped with Zn2+ shows antibacterial activity only against S. aureus in the systems containing Zn2+ ≥ 10 mol %. In addition, PGF doped with Fe3+ rapidly accelerates ex vivo healing in patient chronic wound skin (>30% in 48 h), demonstrating the utility of doped PGF as a potential therapeutic strategy to treat chronic wounds.
The gene encoding mature enterocin P (EntP), an antimicrobial peptide from Enterococcus faecium P13, was cloned into the pPICZalphaA expression vector to generate plasmid pJC31. This plasmid was integrated into the genome of P. pastoris X-33, and EntP was heterologously secreted from the recombinant P. pastoris X-33t1 derivative at a higher production and antagonistic activity than from E. faecium P13.
A segregationally stable expression and secretion vector for Saccharomyces cerevisiae, named pYABD01, was constructed by cloning the yeast gene region encoding the mating pheromone alpha-factor 1 secretion signal (MFalpha1(s)) into the S. cerevisiae high-copy-number expression vector pYES2. The structural genes of the two leaderless peptides of enterocin L50 (EntL50A and EntL50B) from Enterococcus faecium L50 were cloned, separately (entL50A or entL50B) and together (entL50AB), into pYABD01 under the control of the galactose-inducible promoter P(GAL1). The generation of recombinant S. cerevisiae strains heterologously expressing and secreting biologically active EntL50A and EntL50B demonstrates the suitability of the MFalpha1(s)-containing vector pYABD01 to direct processing and secretion of these antimicrobial peptides through the S. cerevisiae Sec system.
The locations of the genetic determinants for enterocin L50 (EntL50A and EntL50B), enterocin Q (EntQ), and enterocin P (EntP) in the multiple bacteriocin producer Enterococcus faecium strain L50 were determined. These bacteriocin genes occur at different locations; entL50AB (encoding EntL50A and EntL50B) are on the 50-kb plasmid pCIZ1, entqA (encoding EntQ) is on the 7.4-kb plasmid pCIZ2, and entP (encoding EntP) is on the chromosome. The complete nucleotide sequence of pCIZ2 was determined to be 7,383 bp long and contains 10 putative open reading frames (ORFs) organized in three distinct regions. The first region contains three ORFs: entqA preceded by two divergently oriented genes, entqB and entqC. EntqB shows high levels of similarity to bacterial ATP-binding cassette (ABC) transporters, while EntqC displays no significant similarity to any known protein. The second region encompasses four ORFs (orf4 to orf7), and ORF4 and ORF5 display high levels of similarity to mobilization proteins from E. faecium and Enterococcus faecalis. In addition, features resembling a transfer origin region (oriT) were found in the promoter area of orf4. The third region contains three ORFs (orf8 to orf10), and ORF8 and ORF9 exhibit similarity to the replication initiator protein RepE from E. faecalis and to RepB proteins, respectively. To clarify the minimum requirement for EntQ synthesis, we subcloned and heterologously expressed a 2,371-bp fragment from pCIZ2 that encompasses only the entqA, entqB, and entqC genes in Lactobacillus sakei, and we demonstrated that this fragment is sufficient for EntQ production. Moreover, we also obtained experimental results indicating that EntqB is involved in ABC transporter-mediated EntQ secretion, while EntqC confers immunity to this bacteriocin.
Dietary protein insufficiency has been linked to excessive triglyceride storage (TG) and non-alcoholic fatty liver disease (NAFLD) in developing countries. Hepatic TG accumulation following a low-protein diet may be due to altered peroxisomal, mitochondrial and gut microbiota function. Hepatic peroxisomes and mitochondria normally mediate metabolism of nutrients to provide energy and substrates for lipogenesis. Peroxisome biogenesis and activities can be modulated by odd (OCFA) and short-chain (SCFA) fatty acids that are derived from gut bacteria e.g. propionate and butyrate. Also produced during amino acid metabolism by peroxisomes and mitochondria, propionate and butyrate correlate with reduced risk of obesity, insulin resistance and NAFLD. In this horizon-scanning review, we have compiled available evidence on the effects of protein malnutrition on OCFA production, arising from loss in mitochondrial, peroxisomal and gut microbiota function, and its association with lipid accumulation in the liver. The methyl donor amino acid composition of dietary protein is an important contributor to liver function and lipid storage; the presence and abundance of dietary branched chain amino acids can modulate the composition and metabolic activity of the gut microbiome and on the other hand, can affect protective OCFA and SCFA production in the liver. In preclinical animal models fed with low protein diets, specific amino acid supplementation can ameliorate fatty liver disease. The association between low dietary protein intake and fatty liver disease is underexplored and merits further investigation, particularly in vulnerable groups with dietary protein restriction in developing countries.
Pregnant ewes were challenged with Chlamydia abortus at 91-98 days of gestation and euthanised at 14, 21 and 28 days post-challenge. IFNγ mRNA labelling appeared to be co-localised with Chlamydial lipopolysaccharide within trophoblast cells in discrete areas lining the primary villi in the limbus and hilar zone of the placentomes from challenged sheep on days 21 and 28 post-infection. The presence of IFNγ was also demonstrated by immunohistochemistry. No labelling was seen in tissues from the non-infected ewes. The presence of IFNγ in trophoblast cells from infected ewes may indicate an attempt to restrict the replication of the organism and be an important trigger for the inflammatory responses that develop on the fetal side of the placenta in enzootic abortion.
The objective of this study was to evaluate the efficacy of plant essential oils (EOs) in combination and to investigate the effect of food ingredients on their efficacy. The EOs assessed in combination included basil, lemon balm, marjoram, oregano, rosemary, sage and thyme. Combinations of EOs were initially screened against Bacillus cereus, Escherichia coli, Listeria monocytogenes and Pseudomonas aeruginosa using the spot-on-agar test. The influence of varying concentrations of EO combinations on efficacy was also monitored using E. coli. These preliminary studies showed promising results for oregano in combination with basil, thyme or marjoram. The checkerboard method was then used to quantify the efficacy of oregano, marjoram or thyme in combination with the remainder of selected EOs. Fractional inhibitory concentrations (FIC) were calculated and interpreted as synergy, addition, indifference or antagonism. All the oregano combinations showed additive efficacy against B. cereus, and oregano combined with marjoram, thyme or basil also had an additive effect against E. coli and P. aeruginosa. The mixtures of marjoram or thyme also displayed additive effects in combination with basil, rosemary or sage against L. monocytogenes. The effect of food ingredients and pH on the antimicrobial efficacy of oregano and thyme was assessed by monitoring the lag phase and the maximum specific growth rate of L. monocytogenes grown in model media. The model media included potato starch (0, 1, 5 or 10%), beef extract (1.5, 3, 6 or 12%), sunflower oil (0, 1, 5 or 10%) and TSB at pH levels of 4, 5, 6 or 7. The antimicrobial efficacy of EOs was found to be a function of ingredient manipulation. Starch and oils concentrations of 5% and 10% had a negative impact on the EO efficacy. On the contrary, the EOs were more effective at high concentrations of protein, and at pH 5, by comparison with pH 6 or 7. This study suggests that combinations of EOs could minimize application concentrations and consequently reduce any adverse sensory impact in food. However, their application for microbial control might be affected by food composition, therefore, careful selection of EOs appropriate to the sensory and compositional status of the food system is required. This work shows that EOs might be more effective against food-borne pathogens and spoilage bacteria when applied to ready to use foods containing a high protein level at acidic pH, as well as lower levels of fats or carbohydrates.
Samples of the intestinal content and carcasses of wood pigeons (Columba palumbus) were evaluated for enterococci with antimicrobial activity. Enterococcus faecium comprised the largest enterococcal species with antagonistic activity, followed by Enterococcusfaecalis and Enterococcus columbae. PCR amplification of genes coding bacteriocins and determination of their nucleotide sequence, and the use of specific antipeptide bacteriocin antibodies and a noncompetitive indirect enzyme-linked immunosorbent assay, permitted characterization of enterococci coding that described bacteriocins and their expression. The efaAfm determinant was the only virulence gene detected in E. faecium, whereas E. faecalis showed a larger number of virulence determinants, and E. columbae did not carry any of the virulence genes examined. Although all E. faecalis isolates manifested a potent direct antimicrobial activity, no activity was detected in supernatants of producer cells. Purification of the antagonistic activity of E. columbae PLCH2 showed multiple chromatographic fragments after matrix-assisted laser desorption-ionization time-of-flight mass spectrometry analysis, suggesting the active peptide(s) had not yet purified to homogeneity. Bacteriocinogenic E. faecium and E. columbae isolates may be considered hygienic for production of enterocins and potentially safe due to their low incidence of potential virulence genes and susceptibility of most relevant clinical antibiotics. However, the presence among the enterococci of E. faecalis strains with a potent antagonistic activity and multiple virulence factors is an issue that must be considered further.
Lactic acid bacteria (LAB) are gut symbionts that can be used as a model to understand the host-microbiota cross talk under unpredictable environmental conditions, such as wildlife ecosystems. The aim of this study was to determine whether viable LAB can be informative of the health status of wild boar populations. We monitored the genotype and phenotype of LAB based on markers that included safety and phylogenetic origin, antibacterial activity, and immunomodulatory properties. A LAB profile dominated by lactobacilli appears to stimulate protective immune responses and relates to strains widely used as probiotics, resulting in a potentially healthy wildlife population, whereas microbiota overpopulated by enterococci was observed in a hostile environment. These enterococci were closely related to pathogenic strains that have developed mechanisms to evade innate immune systems, posing a potential risk for host health. Furthermore, our LAB isolates displayed antibacterial properties in a species-dependent manner. Nearly all of them were able to inhibit bacterial pathogens, raising the possibility of using them as an a la carte antibiotic alternative in the unexplored field of wildlife disease mitigation. Our study highlights that microbiological characterization of LAB is a useful indicator of wildlife health status and the ecological origin from which they derive. The wildlife symbiotic microbiota is an important component for the greater diversity and functionality of their bacterial populations, influencing host health and adaptability to its ecosystem. Although many microbes are partly responsible for the development of multiple physiological processes, only certain bacterial groups, such as lactic acid bacteria (LAB), have the capacity to overpopulate the gut, promoting health (or disease) when specific genetic and environmental conditions are present. LAB have been exploited in many ways due to their probiotic properties, particularly lactobacilli; however, their relationship with wildlife gut-associated microbiota hosts remains to be elucidated. On the other hand, it is unclear whether LAB such as enterococci, which have been associated with detrimental health effects, could lead to disease. These important questions have not been properly considered in the field of wildlife and, therefore, should be clearly addressed.
A novel strategy involving Olive Leaf Extract (OLE) and Cold Atmospheric Plasma (CAP) was developed as a green antimicrobial treatment. Specifically, we reported a preliminary investigation on the combined use of OLE + CAP against three pathogens, chosen to represent medical and food industries (i.e., E. coli, S. aureus and L. innocua). The results indicated that a concentration of 100 mg/mL (total polyphenols) in OLE can exert an antimicrobial activity, but still insufficient for a total bacterial inactivation. By using plain OLE, we significantly reduced the growth of Gram positive S. aureus and L. innocua, but not Gram-negative E. coli. Instead, we demonstrated a remarkable decontamination effect of OLE + CAP in E. coli, S. aureus and L. innocua samples after 6 h. This effect was optimally maintained up to 24 h in S. aureus strain. E. coli and L. innocua grew again in 24 h. In the latter strain, OLE alone was most effective to significantly reduce bacterial growth. By further adjusting the parameters of OLE + CAP technology, e.g., OLE amount and CAP exposure, it could be possible to prolong the initial powerful decontamination over a longer time. Since OLE derives from a bio-waste and CAP is a non-thermal technology based on ionized air, we propose OLE + CAP as a potential green platform for bacterial decontamination. As a combination, OLE and CAP can lead to better antimicrobial activity than individually and may replace or complement conventional thermal procedures in food and biomedical industries.
Type-I interferon (IFN-I) cytokines are produced by immune cells in response to microbial infections, cancer and autoimmune diseases, and subsequently, trigger cytoprotective and antiviral responses through the activation of IFN-I stimulated genes (ISGs). The ability of intestinal microbiota to modulate innate immune responses is well known, but the mechanisms underlying such responses remain elusive. Here we report that the intracellular sensors stimulator of IFN genes (STING) and mitochondrial antiviral signaling (MAVS) are essential for the production of IFN-I in response to lactic acid bacteria (LAB), common gut commensal bacteria with beneficial properties. Using human macrophage cells we show that LAB strains that potently activate the inflammatory transcription factor NF-κB are poor inducers of IFN-I and conversely, those triggering significant amounts of IFN-I fail to activate NF-κB. This IFN-I response is also observed in human primary macrophages, which modulate CD64 and CD40 upon challenge with IFN-I-inducing LAB. Mechanistically, IFN-I inducers interact more intimately with phagocytes as compared to NF-κB-inducers, and fail to activate IFN-I in the presence of phagocytosis inhibitors. These bacteria are then sensed intracellularly by the cytoplasmic sensors STING and, to a lesser extent, MAVS. Accordingly, macrophages deficient for STING showed dramatically reduced phosphorylation of TANK-binding kinase (TBK)-1 and IFN-I activation, which resulted in lower expression of ISGs. Our findings demonstrate a major role for intracellular sensing and STING in the production of IFN-I by beneficial bacteria and the existence of bacteria-specific immune signatures, which can be exploited to promote cytoprotective responses and prevent overreactive NF-κB-dependent inflammation in the gut.
The aim of this study was to optimise the antimicrobial efficacy of plant essential oils (EOs) for control of Listeria spp. and spoilage bacteria using food model media based on lettuce, meat and milk. The EOs evaluated were lemon balm, marjoram, oregano and thyme and their minimum inhibitory concentrations (MIC) were determined against Enterobacter spp., Listeria spp., Lactobacillus spp., and Pseudomonas spp. using the agar dilution method and/or the absorbance based microplate assay. MICs were significantly lower in lettuce and beef media than in TSB. Listeria strains were more sensitive than spoilage bacteria, and oregano and thyme were the most active EOs. EO combinations were investigated using the checkerboard method and Oregano combined with thyme had additive effects against spoilage organisms. Combining lemon balm with thyme yielded additive activity against Listeria strains. The effect of simple sugars and pH on antimicrobial efficacy of oregano and thyme was assessed in a beef extract and tomato serum model media. EOs retained greater efficacy at pH 5 and 2.32% sugar, but sugar concentrations above 5% did not negatively impact EO efficacy. In addition to proven antimicrobial efficacy, careful selection and investigation of EOs appropriate to the sensory profile of foods and composition of the food system is required. This work shows that EOs might be more effective against food-borne pathogens and spoilage bacteria when applied to foods containing a high protein level at acidic pH, as well as moderate levels of simple sugars.
A real-time PCR (rt-PCR) targeting the 529-bp repeat element (RE) of Toxoplasma gondii was used to detect and quantify the parasite burden in maternal and foetal tissues in 18 seronegative ewes infected with 3000 toxoplasma oocysts on day 90 of pregnancy. The infected ewes were sacrificed in groups of 4-6 at 21, 25, 33 and 35 days post-challenge. Ten sham inoculated pregnant ewes were used as controls. T. gondii was not detected in the control ewes or their foeti. The parasite was only detected in the maternal tissues in a few of the challenged ewes on a small number of occasions where it was identified in spleen and uterine lymph nodes. T. gondii was detected in the foetal spleen and liver at the early sacrifice times but only sporadically thereafter. In the case of amniotic, allantoic and foetal aqueous humor samples T. gondii was only detected on a small number of occasions. However, it was found in the majority of the foetal lung and placentome samples throughout the study period, while placentomes and foetal brains contained high levels of the parasite during the later stages. Histopathological examination of placentome and brain tissue from the foeti in the present study revealed a strong correlation between histopathological lesions and quantities of the parasite DNA detected. These results indicate that the cotyledonary component of the foetal membranes is the sample of choice for the diagnosis of T. gondii by rt-PCR, followed by foetal lung and brain.
The objectives of this study were to evaluate the efficacy of plant essential oils (EOs) for control of the natural spoilage microflora on ready-to-eat (RTE) lettuce and carrots whilst also considering their impact on organoleptic properties. Initial decontamination effects achieved using EOs were comparable to that observed with chlorine and solution containing oregano recorded a significantly lower initial TVC level than the water treatment on carrots (p < 0.05). No significant differences were found between the EO treatments and chlorine considering gas composition, color, texture and water activity of samples. The sensory panel found EO treatments acceptable for carrots throughout storage, while lettuce washed with the EO solutions were rejected for overall appreciation by Day 7. Correlating microbial and sensory changes with volatile emissions identified 12 volatile quality markers. Oregano might be a suitable decontamination alternative to chlorine for RTE carrots, while the identification of volatile quality markers is a useful complement to sensory and microbiological assessments in the monitoring of organoleptic property changes and shelf-life of fresh vegetables. Industrial relevance: There is industrial demand for natural alternatives to chlorine, which is commonly used for decontamination of fresh produce but which has limitations with respect to antimicrobial efficacy and possible formation of carcinogenic compounds in water. Plant essential oils have proven antimicrobial and other bioactive properties, however their usefulness in foods can be mitigated by their high sensory impact. This study examined the application of EOs for fresh produce decontamination addressing control of spoilage microflora and improving shelf-life characteristics whilst also considering the impact on organoleptic properties. The effectiveness of oregano as a decontamination treatment was comparable with that of chlorine. Carrot discs treated with the EO regimes were acceptable in terms of sensory quality and appreciation, therefore oregano could offer a natural alternative for the washing and preservation of fresh produce. Combining EOs with other natural preservatives might minimize doses and reduce the impact on organoleptic properties of fresh vegetables. © 2008 Elsevier Ltd. All rights reserved.
Chlamydophila abortus is an intracellular pathogen and the etiological agent of enzootic abortion of ewes (EAE). C. abortus has a biphasic development cycle; extracellular infectious elementary bodies (EB) attach and penetrate host cells, where they give rise to intracellular, metabolically active reticulate bodies (RB). RB divide by binary fission and subsequently mature to EB, which, on rupture of infected cells, are released to infect new host cells. Pregnant ewes were challenged with 2 x 10(6) inclusion forming units (IFU) of C. abortus cultured in yolk sac (comprising both EB and RB). Serum samples were collected at 0, 7, 14, 21, 27, 30, 35, 40, and 43 days postinfection (dpi) and used to identify antigens of C. abortus expressed during disease. Additionally, sera from fetal lambs were collected at 30, 35, 40, and 43 dpi. All serum samples collected from experimentally infected pregnant ewes reacted specifically with several antigens of EB as determined by one-dimensional (1-D) and 2-D gel electrophoresis; reactive antigens identified by mass spectrometry included the major outer membrane protein (MOMP), polymorphic outer membrane protein (POMP), and macrophage infectivity potentiator (MIP) lipoprotein.
Six ovine fetal brains were harvested 33 to 35 days postchallenge from 5 ewes, each of which was given 3000 Toxoplasma gondii oocysts on day 90 of pregnancy. Histopathologic examination of transverse sections taken at 13 levels in the fetal brains revealed the presence of toxoplasmosis-related lesions in all 6 brains. However, lesions were not randomly distributed (P = .007); they were most numerous at the level of the optic tract, the rostral margin of the pons, and 4 mm caudal to the ansate sulcus and were absent in all sections at the level of the caudal cerebellum. Lesion distribution may be due to hemodynamic factors, differences in the expression of endothelial surface receptor molecules at the level of the blood-brain barrier, or the presence of localized permissive/inhibitory factors within the brain. The results have implications for the selection of areas of brain from aborted ovine fetuses to be examined histopathologically for laboratory diagnosis.
The World Health Organization warns that the alarming increase in antibiotic resistant bacteria will lead to 2.7 million deaths annually due to the lack of effective antibiotic therapies. Clearly, there is an urgent need for short-term alternatives that help to alleviate these alarming figures. In this respect, the scientific community is exploring neglected ecological niches from which the prototypical antibiotic-producing bacteria Streptomycetes are expected to be present. Recent studies have reported that honeybees and their products carry Streptomyces species that possess strong antibacterial activity. In this study, we have investigated the antibiotic profile of two Streptomycetes strains that were isolated from beehives. One of the isolates is the strain Streptomyces albus AN1, which derives from pollen, and shows potent antimicrobial activity against Candida albicans . The other isolate is the strain Streptomyces griseoaurantiacus AD2, which was isolated from honey, and displays a broad range of antimicrobial activity against different Gram-positive bacteria, including pathogens such as Staphylococcus aureus and Enterococus faecalis . Cultures of S. griseoaurantiacus AD2 have the capacity to produce the antibacterial compounds undecylprodigiosin and manumycin, while those of S. albus AN1 accumulate antifungal compounds such as candicidins and antimycins. Furthermore, genome and dereplication analyses suggest that the number of putative bioactive metabolites produced by AD2 and AN1 is considerably high, including compounds with anti-microbial and anti-cancer properties. Our results postulate that beehives are a promising source for the discovery of novel bioactive compounds that might be of interest to the agri-food sector and healthcare pharmaceuticals.
Two efficient feather-degrading bacteria were isolated from honeybee samples and identified as Bacillus sonorensis and Bacillus licheniformis based on 16S rRNA and genome sequencing. The strains were able to grow on chicken feathers as the sole carbon and nitrogen sources and degraded the feathers in a few days. The highest keratinase activity was detected by the B. licheniformis CG1 strain (3800 U x mL(-1)), followed by B. sonorensis AB7 (1450 U x mL(-1)). Keratinase from B. licheniformis CG1 was shown to be active across a wide range of pH, potentially making this strain advantageous for further industrial applications. All isolates displayed antimicrobial activity against Micrococcus luteus; however, only B. licheniformis CG1 was able to inhibit the growth of Mycobacterium smegmatis. In silico analysis using BAGEL and antiSMASH identified gene clusters associated with the synthesis of non-ribosomal peptide synthetases (NRPS), polyketide synthases (PKSs) and/or ribosomally synthesized and post-translationally modified peptides (RiPPs) in most of the Bacillus isolates. B. licheniformis CG1, the only strain that inhibited the growth of the mycobacterial strain, contained sequences with 100% similarity to lichenysin (also present in the other isolates) and lichenicidin (only present in the CG1 strain). Both compounds have been described to display antimicrobial activity against distinct bacteria. In summary, in this work, we have isolated a strain (B. licheniformis CG1) with promising potential for use in different industrial applications, including animal nutrition, leather processing, detergent formulation and feather degradation.
The objectives of this study were to evaluate the antimicrobial activity of plant essential oils (EOs) against foodborne pathogens and key spoilage bacteria pertinent to ready-to-eat vegetables and to screen the selected EOs for sensory acceptability. The EOs basil, caraway, fennel, lemon balm, marjoram, nutmeg, oregano, parsley, rosemary, sage, and thyme were evaluated. The bacteria evaluated were Listeria spp., Staphylococcus aureus, Lactobacillus spp., Bacillus cereus, Salmonella, Enterobacter spp., Escherichia coli, and Pseudomonas spp. Quantitative antimicrobial analyses were performed using an absorbance-based microplate assay. Efficacy was compared using MIC, the half maximum inhibitory concentration, and the increase in lag phase. Generally, gram-positive bacteria were more sensitive to EOs than were gram-negative bacteria, and Listeria monocytogenes strains were among the most sensitive. Of the spoilage organisms, Pseudomonas spp. were the most resistant. Oregano and thyme EOs had the highest activity against all the tested bacteria. Marjoram and basil EOs had selectively high activity against B. cereus, Enterobacter aerogenes, E. coli, and Salmonella, and lemon balm and sage EOs had adequate activity against L. monocytogenes and S. aureus. Within bacterial species, EO efficacy was dependent on strain and in some cases the origin of the strain. On a carrot model product, basil, lemon balm, marjoram, oregano, and thyme EOs were deemed organoleptically acceptable, but only oregano and marjoram EOs were deemed acceptable for lettuce. Selected EOs may be useful as natural and safe additives for promoting the safety and quality of ready-to-eat vegetables.
Enterocin P (EntP), a sec-dependent bacteriocin from Enterococcus faecium P13, was produced by Lactococcus lactis. The EntP structural gene (entP) with or without the EntP immunity gene (entiP) was cloned in (1), plasmid pMG36c under control of the lactococcal constitutive promoter P32, (2) in plasmid pNG8048e under control of the inducible PnisA promoter, and (3) in the integration vector pINT29. Introduction of the recombinant vectors in L. lactis resulted in production of biologically active EntP in the supernatants of L. lactis subsp. lactis IL1403 and L. lactis subsp. cremoris NZ9000, and the coproduction of nisin A and EntP in L. lactis subsp. lactis DPC5598. The level of production of EntP, detected and quantified by specific anti-EntP antibodies and a noncompetitive indirect enzyme-linked immunosorbent assay, by the recombinant L. lactis strains depended on the host strain, the expression vector, and the presence of the entiP gene in the constructs of the recombinant L. lactis strains. The highest amount of EntP was produced with derivatives containing entP and entiP, for both L. lactis IL1403 and L. lactis NZ9000. These derivatives produced up to five- to six-fold more EntP than E. faecium P13. Mass spectrometry analysis revealed that EntP purified from L. lactis IL1403 (pJP214) has a molecular mass identical to that purified from E. faecium P13, suggesting that the synthesis, processing, and secretion of EntP progresses efficiently in recombinant L. lactis hosts.
Mesoporous glasses are a promising class of bioresorbable biomaterials characterized by high surface area and extended porosity in the range of 2 to 50 nm. These peculiar properties make them ideal materials for the controlled release of therapeutic ions and molecules. Whilst mesoporous silicate-based glasses (MSG) have been widely investigated, much less work has been done on mesoporous phosphate-based glasses (MPG). In the present study, MPG in the P 2 O 5 –CaO–Na 2 O system, undoped and doped with 1, 3, and 5 mol% of Cu ions were synthesized via a combination of the sol–gel method and supramolecular templating. The non-ionic triblock copolymer Pluronic P123 was used as a templating agent. The porous structure was studied via a combination of Scanning Electron Microscopy (SEM), Small-Angle X-ray Scattering (SAXS), and N 2 adsorption–desorption analysis at 77 K. The structure of the phosphate network was investigated via solid state 31 P Magic Angle Spinning Nuclear Magnetic Resonance ( 31 P MAS-NMR) and Fourier Transform Infrared (FTIR) spectroscopy. Degradation studies, performed in water via Inductively Coupled Plasma-Optical Emission Spectroscopy (ICP-OES), showed that phosphates, Ca 2+ , Na + and Cu ions are released in a controlled manner over a 7 days period. The controlled release of Cu, proportional to the copper loading, imbues antibacterial properties to MPG. A significant statistical reduction of Staphylococcus aureus ( S. aureus ) and Escherichia coli ( E. coli ) bacterial viability was observed over a 3 days period. E. coli appeared to be more resistant than S. aureus to the antibacterial effect of copper. This study shows that copper doped MPG have great potential as bioresorbable materials for controlled delivery of antibacterial ions.
Concerns regarding the role of antimicrobial resistance (AMR) in disease outbreaks are growing due to the excessive use of antibiotics. Moreover, consumers are demanding food products that are minimally processed and produced in a sustainable way, without the use of chemical preservatives or antibiotics. Grape seed extract (GSE) is isolated from wine industry waste and is an interesting source of natural antimicrobials, especially when aiming to increase sustainable processing. The aim of this study was to obtain a systematic understanding of the microbial inactivation efficacy/potential of GSE against Listeria monocytogenes (Gram-positive), Escherichia coli and Salmonella Typhimurium (Gram-negative) in an in vitro model system. More specifically, for L. monocytogenes, the effects of the initial inoculum concentration, bacterial growth phase and absence of the environmental stress response regulon (SigB) on the GSE microbial inactivation potential were investigated. In general, GSE was found to be highly effective at inactivating L. monocytogenes, with higher inactivation achieved for higher GSE concentrations and lower initial inoculum levels. Generally, stationary phase cells were more resistant/tolerant to GSE as compared to exponential phase cells (for the same inoculum level). Additionally, SigB appears to play an important role in the resistance of L. monocytogenes to GSE. The Gram-negative bacteria under study (E. coli and S. Typhimurium) were less susceptible to GSE as compared to L. monocytogenes. Our findings provide a quantitative and mechanistic understanding of the impact of GSE on the microbial dynamics of foodborne pathogens, assisting in the more systematic design of natural antimicrobial-based strategies for sustainable food safety.
Probiotics represent a non-invasive, environmentally-friendly alternative to reduce infectious diseases in wildlife species. Our aim was to evaluate the potential of typical gut commensals, such as lactic acid bacteria (LAB), as wildlife probiotics. The selected LAB were isolated from European badgers (Meles meles); a wildlife reservoir of bovine tuberculosis, and comprised four different genera: Enterococcus; Weissella; Pediococcus; and Lactobacillus. The enterococci displayed a phenotype and genotype that correlate with the production of antibacterial peptides and stimulation of antiviral responses. However, these isolates carry virulence and antibiotic resistance genes. Weissella showed some anti-mycobacterial activity due to their ability to produce lactate and ethanol. Interestingly, lactobacilli and pediococci modulated pro-inflammatory phagocytic responses that associate with protection against pathogens; and these responses agreed with the presence of immunomodulatory markers in their genomes. Although both lactobacilli and pediococci showed tolerance to antibiotics, this resistance was naturally acquired and almost all isolates possessed a strong phylogenetic relationship with isolates from food and healthy animals. Our results show that LAB display probiotic benefits that depend on the genera. Lactobacilli and pediococci are probably the most interesting candidates as probiotics against infectious diseases in wildlife because of their food-grade status and ability to modulate protective innate immune responses.
The study aimed to explore the antimicrobial efficacy of grape seed extract (GSE) and cold atmospheric plasma (CAP) individually or in combination against L. monocytogenes and E. coli wild type (WT) and their isogenic mutants in environmental stress genes. More specifically, we examined the effects of 1% (wt/vol) GSE, 4 min of CAP treatment, and their combined effect on L. monocytogenes 10403S WT and its isogenic mutants ΔsigB, ΔgadD1, ΔgadD2, ΔgadD3, as well as E. coli K12 and its isogenic mutants ΔrpoS, ΔoxyR, and ΔdnaK. In addition, the sequence of the combined treatments was tested. A synergistic effect was achieved for all L. monocytogenes strains when exposure to GSE was followed by CAP treatment. However, the same effect was observed against E. coli strains, only for the reversed treatment sequence. Additionally, L. monocytogenes ΔsigB was more sensitive to the individual GSE and the combined GSE/CAP treatment, whereas ΔgadD2 was more sensitive to CAP, as compared to the rest of the mutants under study. Individual GSE exposure was unable to inhibit E. coli strains, and individual CAP treatment resulted in higher inactivation of E. coli in comparison to L. monocytogenes with the strain ΔrpoS appearing the most sensitive among all studied strains. Our findings provide a step toward a better understanding of the mechanisms playing a role in the tolerance/sensitivity of our model Gram-positive and Gram-negative bacteria toward GSE, CAP, and their combination. Therefore, our results contribute to the development of more effective and targeted antimicrobial strategies for sustainable decontamination.
The demand for products that are minimally processed and produced in a sustainable way, without the use of chemical preservatives or antibiotics have increased over the last years. Novel non-thermal technologies such as cold atmospheric plasma (CAP) and natural antimicrobials such as grape seed extract (GSE) are attractive alternatives to conventional food decontamination methods as they can meet the above demands. The aim of this study was to investigate the microbial inactivation potential of GSE, CAP (in this case, a remote air plasma with an ozone-dominated RONS output) and their combination against L. monocytogenes on five different 3D in vitro models of varying rheological, structural, and biochemical composition. More specifically, we studied the microbial dynamics, as affected by 1 % (w/v) GSE, CAP or their combination, in three monophasic Xanthan Gum (XG) based 3D models of relatively low viscosity (1.5 %, 2.5 % and 5 % w/v XG) and in a biphasic XG/Whey Protein (WPI) and a triphasic XG/WPI/fat model. A significant microbial inactivation (comparable to liquid broth) was achieved in presence of GSE on the surface of all monophasic models regardless of their viscosity. In contrast, the GSE antimicrobial effect was diminished in the multiphasic systems, resulting to only a slight disturbance of the microbial growth. In contrast, CAP showed better antimicrobial potential on the surface of the complex multiphasic models as compared to the monophasic models. When combined, in a hurdle approach, GSE/CAP showed promising microbial inactivation potential in all our 3D models, but less microbial inactivation in the structurally and biochemically complex multiphasic models, with respect to the monophasic models. The level of inactivation also depended on the duration of the exposure to GSE. Our results contribute towards understanding the antimicrobial efficacy of GSE, CAP and their combination as affected by robustly controlled changes of rheological and structural properties and of the biochemical composition of the environment in which bacteria grow. Therefore, our results contribute to the development of sustainable food safety strategies.